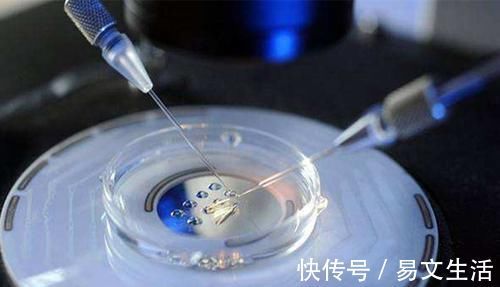
科学|中国首位“试管婴儿”,如今已31岁,与自然受孕的普通人有差别吗

科学|中国首位“试管婴儿”,如今已31岁,与自然受孕的普通人有差别吗
虽说如今为了改善怀孕难和分娩难的问题,试管婴儿、剖腹产、无痛分娩的应用率越来越广。
但仍然有部分思想比较传统的人,尤其是老人,对试管婴儿以及无痛分娩等存在巨大误解,哪怕这种医学技术已经应用了几十年,达到十分纯熟的地步,仍然会在医院听到一些老人们不科学的言论。
其实,试管婴儿已经经历过了时间的考验。中国首例成功的试管婴儿案例发生在1988年,这个女孩叫郑萌珠,如今已经31岁了。
【 科学|中国首位“试管婴儿”,如今已31岁,与自然受孕的普通人有差别吗】

文章插图
那么,她与自然受孕的普通人有差别吗?现实可能和你想的不一样。
据郑萌珠表示,一开始她对自己试管婴儿的称呼也不是很习惯,如今已过而立之年,对她而言这个称呼已经没什么特殊的感觉了。
现在她也成为了一位母亲,抱着自己的孩子,在镜头面前笑靥如花,看起来生活还是非常幸福的。

文章插图
郑萌珠表示,她觉得自己和自然受孕的普通孩子没什么太大区别,身体健康、学习顺利、生活幸福。尤其如今试管婴儿的技术已经非常成熟,没必要抱有偏见,自己的案例已经从侧面表明了其先进程度。
跟大部分的婴儿一样,试管婴儿同样可以自由自在地生活。
1)寿命短?
很多人认为试管婴儿会比正常婴儿的寿命短一些,可这样的说法没有任何科学根据,也没有事实证明,纯粹只是妄自揣测而已。
首先,无论自然受孕的孩子还是试管婴儿,都无法控制自己寿命的长短。
再者,试管婴儿也是精子与卵子相结合形成的受精卵,只不过是体外受精的而已。而且整个培育是无菌的,防止外界环境干扰,如果有问题也只能说明双方家长存在问题,而不是技术原因。

文章插图
2)智力低下?
部分人认为试管婴儿是通过科学手段诞生的婴儿,仪器会对大脑造成一定辐射损伤。但只要稍微动些脑子,就会知道这样的说法完全是没道理的。
首先,试管婴儿除了受精和初步的培育阶段是在体外进行的,其余时间都在妈妈的体内发育。
再者,就算这些科学设备真的存在辐射,此时胎儿也还没有开始生长发育,几乎不会受到影响。
可以说,试管婴儿与普通自然受孕的婴儿,不存在什么差别。对难以怀孕的夫妻而言,这是如今最合适也是最科学的项目。
当然,它仍然不能解决怀孕难的所有问题。部分存在特殊情况的夫妻,是无法选择试管婴儿的。

文章插图
1)某一方存在生殖性传染病
夫妻双方只要有一人具备生殖性传染病,医院就不会提供试管婴儿技术。
这是因为精子和卵子带有致病基因结合后,孩子也很容易患上同类疾病,从人道主义的角度来说,这是对孩子的一种不负责任。
因而,这种情况下,无论家长还是医院都必须慎重考虑。
2)长期酗酒
对那些长期酗酒、拥有不良生活习惯的夫妻而言,由于生殖细胞的活性比较低,生存能力不强,即使从体内提取出来,也不一定会受孕成功。
因而,如果打算备孕,不论自然受孕还是做试管婴儿,戒掉不良习惯是头等大事。
- 什么|这些谣言你都听过吗?妈妈网孕育破解网传谣言,帮你科学助孕
- 崔玉涛推荐【月子手册】42天科学坐月子
- 同事|这种“中国式哄睡”容易伤害孩子的大脑,家长别害了娃还不自知
- 分析|2022-2028年中国幼儿园(幼教)市场研究与市场运营趋势报告
- 科学育儿有讲究,孕期怎么吃,生出的宝宝才漂亮又健康呢
- 脑科学家证实:经常催孩子,孩子会越来越笨,到底有多可怕
- 儿童面条怎么选,家长要避开噱头,科学选择并为宝宝健康保驾护航
- 妈妈,你为什么这么焦虑?因为上了“科学”育儿的当
- 疫情|科学防疫丨疫情防控再提示
- 中国新生儿出生率创新低!年轻人的生育意愿降低!